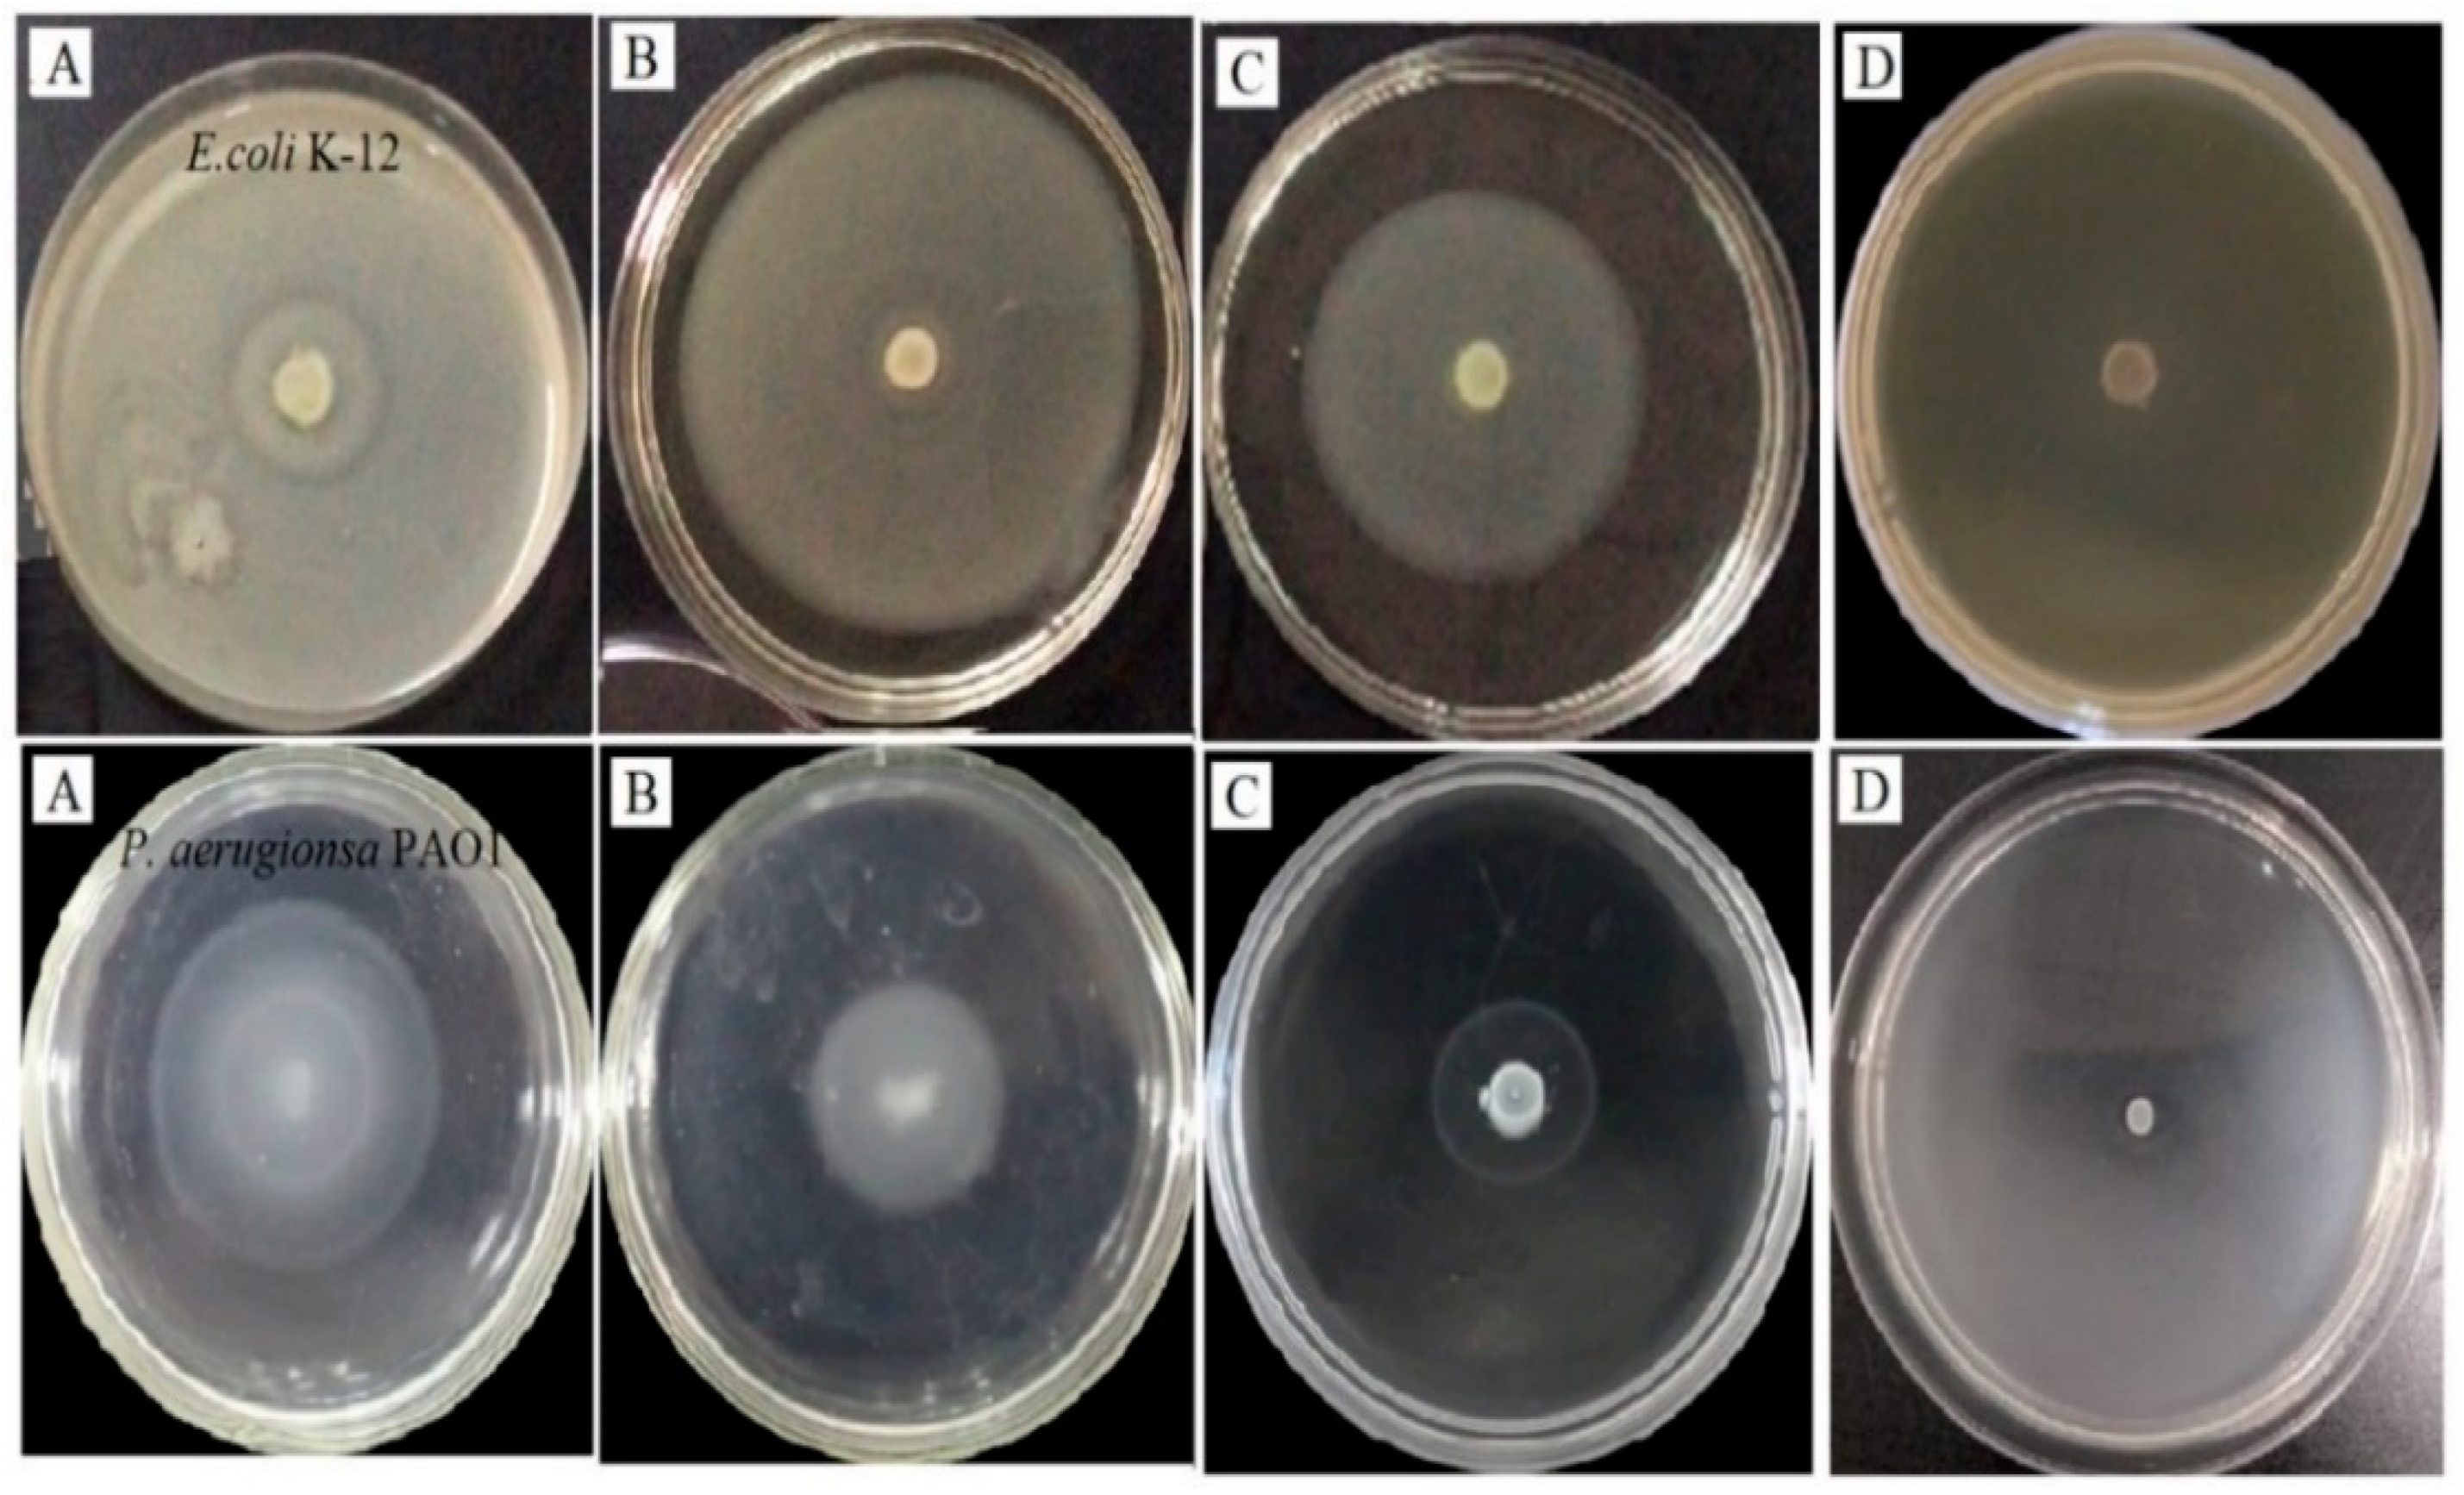
Molecules 25 04727 g003 Molecules 25 04727 g003
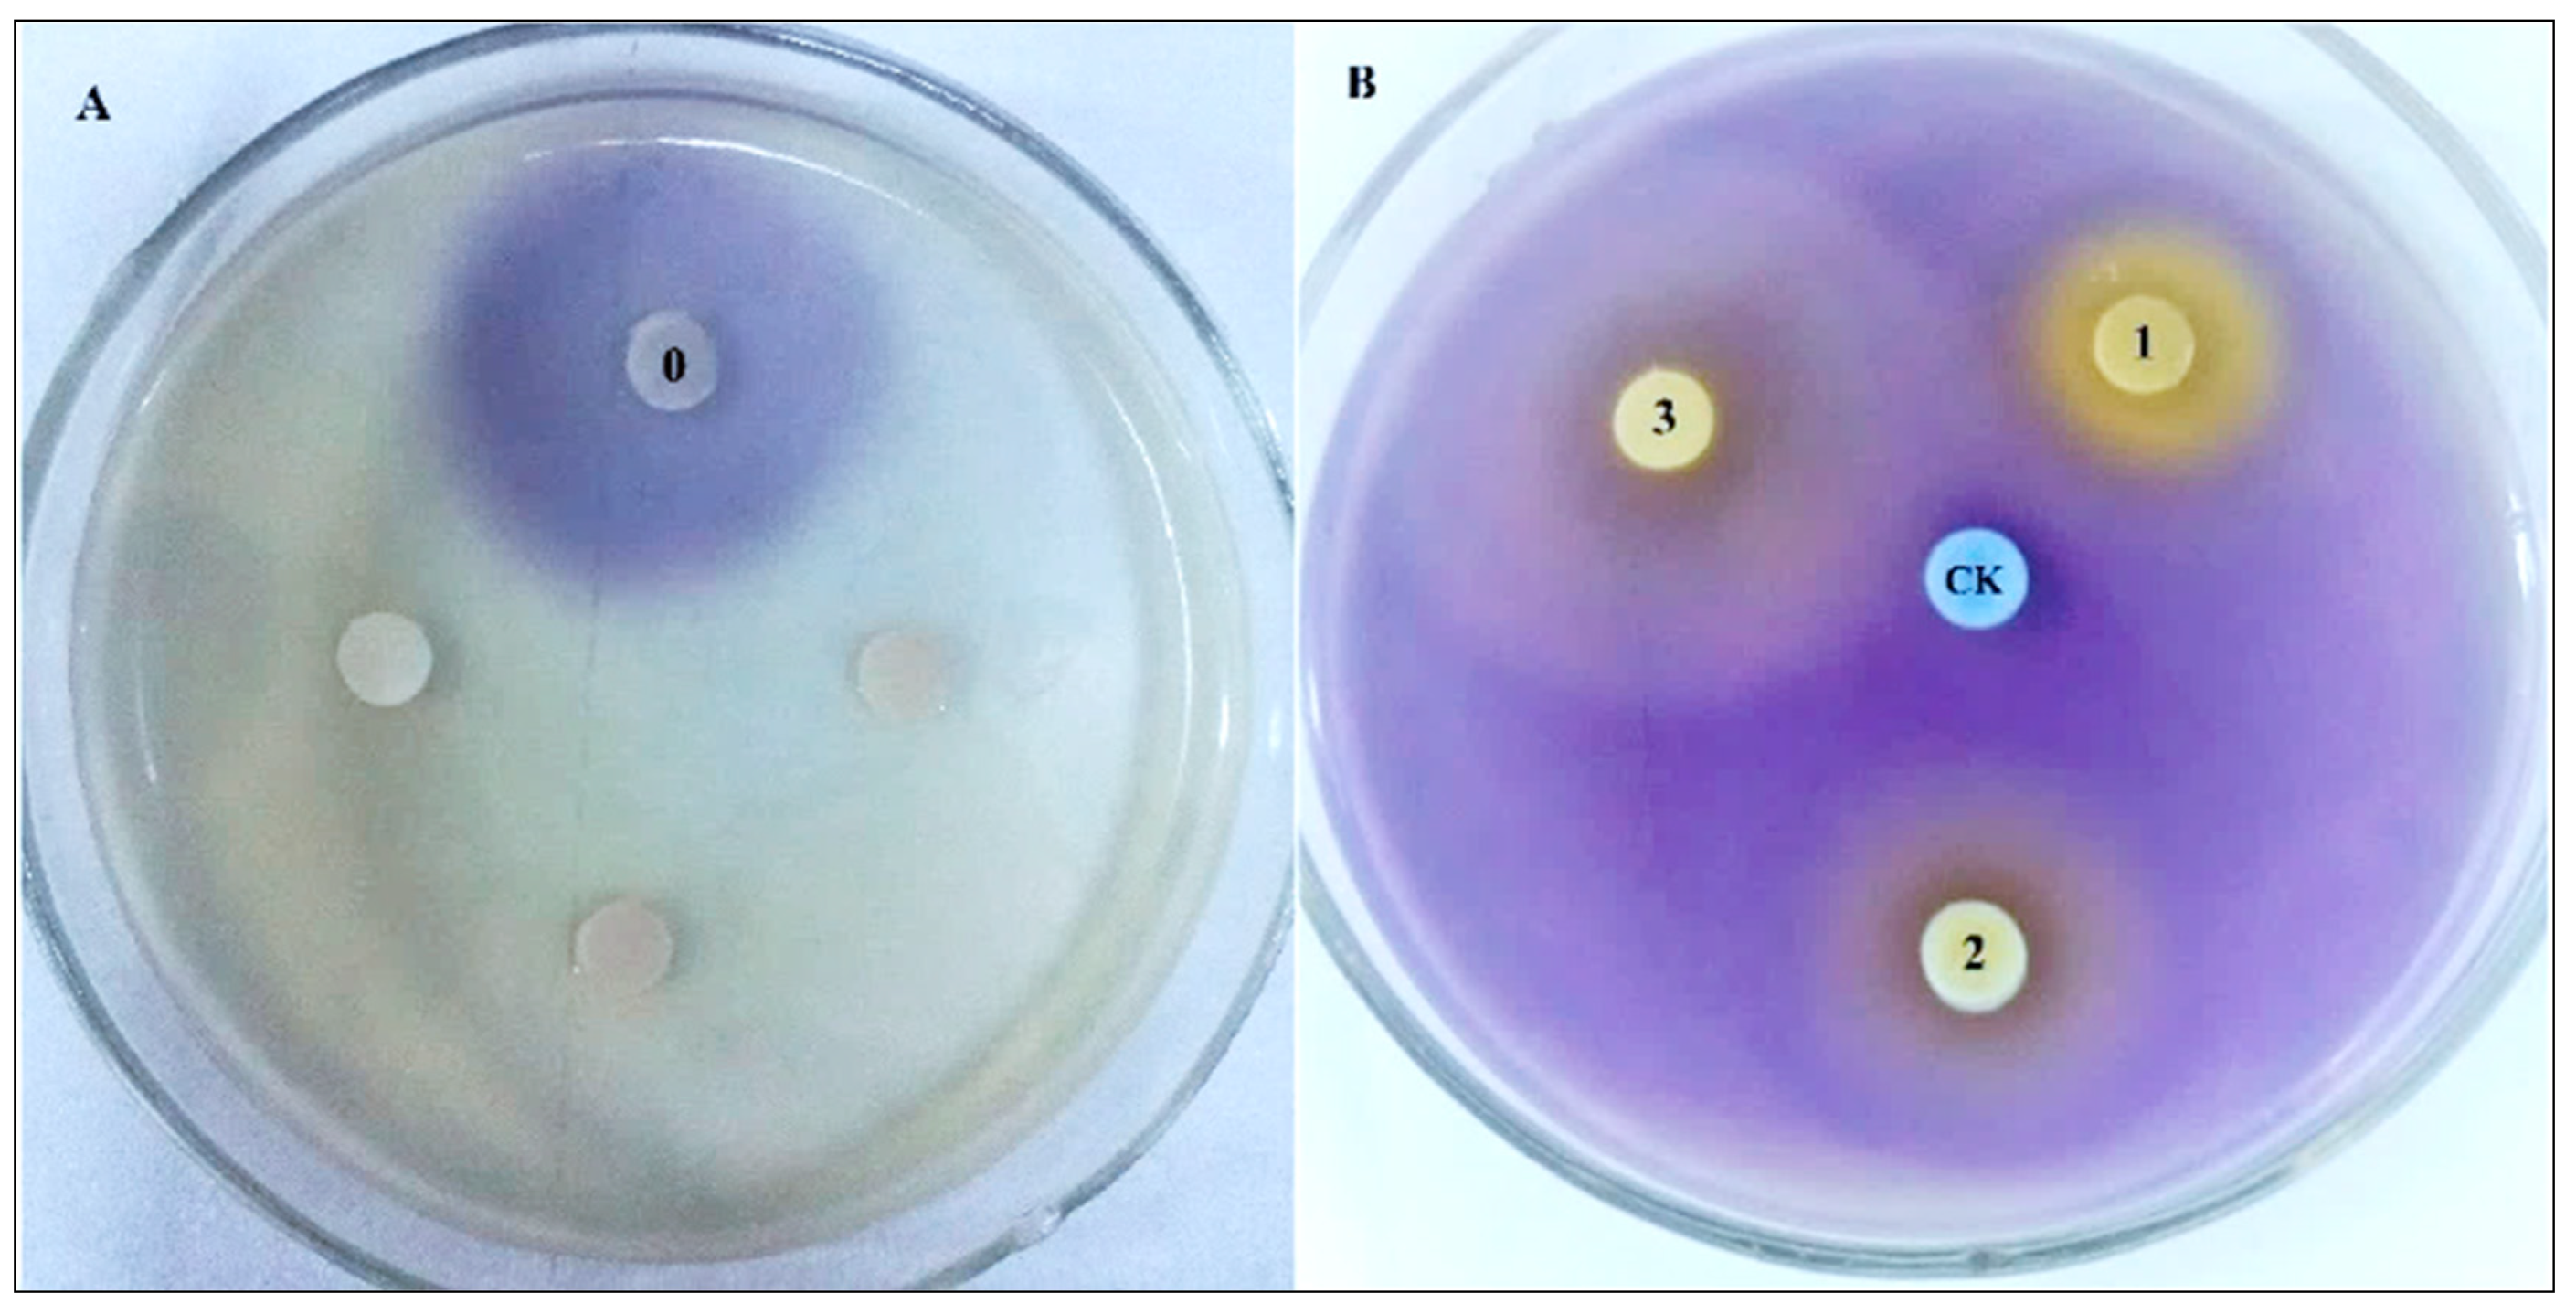
Molecules 25 04727 g007 Molecules 25 04727 g007

Ethanol Extract of Campsis grandiflora Flower and Its Organic Acid Components Have Inhibitory Effects on Autoinducer Type 1 Quorum Sensing
Abstract
1. Introduction
2. Results and Discussion
2.1. QSIs Screening
2.2. The QSI Activities of CFEE
2.3. CFEE Inhibits the Yield of Violacein in C. violaceum 026
2.4. CFEE Interrupts the Swarming Ability of Tested Strains
2.5. CFEE Interrupts Biofilm Formation in Tested Strains
2.6. CFEE Scavenging Capacity on Biofilms of Tested Strains
2.7. CFEE Chemical Composition
2.8. QSI Activities of Malic Acid and Succinic Acid
3. Materials and Methods
3.1. Materials, Test Strains, Culture Media, and Growth Conditions
3.2. Crude Extract Preparation from the Chinese Herbal Medicines
3.3. Screening for QSIs
3.4. CFEE Preparation
3.5. Determination of Total Polyphenol Content of CFEE
3.6. Determination of the MIC of CFEE
3.7. QSI Assay
3.8. Swarming Motility Inhibition Assay
3.9. Biofilm Formation Inhibition Assay
3.10. Determination of the Scavenging Capacity of CFEE on the Mature Biofilms
3.11. CFEE Components Assay by UHPLC-MS/MS
3.12. Statistical Evaluations
4. Conclusions
Supplementary Materials
Author Contributions
Funding
Acknowledgments
Conflicts of Interest
References
- Defoirdt, T. Quorum-Sensing Systems as Targets for Antivirulence Therapy. Trends Microbiol. 2018, 26, 313–328. [Google Scholar] [CrossRef] [PubMed]
- Hancock, R.E.W. Collateral damage. Nat. Biotechnol. 2014, 32, 66–68. [Google Scholar] [CrossRef] [PubMed]
- Wan, T.; Liu, Z.-M.; Li, L.; Leitch, A.R.; Leitch, A.R.; Lohaus, R.; Liu, Z.-J.; Xin, H.-P.; Gong, Y.-B.; Liu, Y.; et al. A genome for gnetophytes and early evolution of seed plants. Nat. Plants 2018, 4, 82–89. [Google Scholar] [CrossRef] [PubMed]
- Yan, M.; Wang, X.; Deng, J.; Wang, L.; Cui, Z.; Shi, Z. DNA methylation and cerebellar development, the regulation of Notch and Shh pathway. Ital. J. Zoöl. 2016, 83, 34–42. [Google Scholar] [CrossRef]
- Song, Y.; Miao, Y.; Song, C.-P. Behind the scenes: The roles of reactive oxygen species in guard cells. New Phytol. 2013, 201, 1121–1140. [Google Scholar] [CrossRef] [PubMed]
- Ćirić, A.; Petrović, J.; Glamočlija, J.; Ivanov, M.; Nikolić, M.; Stojković, D.; Petrović, J. Natural products as biofilm formation antagonists and regulators of quorum sensing functions: A comprehensive review update and future trends. South. Afr. J. Bot. 2019, 120, 65–80. [Google Scholar] [CrossRef]
- Wang, H.-H.; Ye, K.-P.; Zhang, Q.-Q.; Dong, Y.; Xu, X.-L.; Zhou, G.-H. Biofilm formation of meat-borne Salmonella enterica and inhibition by the cell-free supernatant from Pseudomonas aeruginosa. Food Control 2013, 32, 650–658. [Google Scholar] [CrossRef]
- Høiby, N.; Bjarnsholt, T.; Givskov, M.; Molin, S.; Ciofu, O. Antibiotic resistance of bacterial biofilms. Int. J. Antimicrob. Agents 2010, 35, 322–332. [Google Scholar] [CrossRef]
- De Kievit, T.R.; Iglewski, B.H. Bacterial Quorum Sensing in Pathogenic Relationships. Infect. Immun. 2000, 68, 4839–4849. [Google Scholar] [CrossRef]
- Bakkiyaraj, D.; Sivasankar, C.; Pandian, S.K. Inhibition of quorum sensing regulated biofilm formation in Serratia marcescens causing nosocomial infections. Bioorganic Med. Chem. Lett. 2012, 22, 3089–3094. [Google Scholar] [CrossRef]
- Sharif, D.I.; Gallon, J.; Smith, C.J.; Dudley, E. Quorum sensing in Cyanobacteria: N-octanoyl-homoserine lactone release and response, by the epilithic colonial cyanobacterium Gloeothece PCC6909. ISME J. 2008, 2, 1171–1182. [Google Scholar] [CrossRef] [PubMed]
- Brindhadevi, K.; LewisOscar, F.; Mylonakis, E.; Shanmugam, S.; Verma, T.N.; Pugazhendhi, A. Biofilm and Quorum sensing mediated pathogenicity in Pseudomonas aeruginosa. Process Biochem. 2020, 96, 49–57. [Google Scholar] [CrossRef]
- Saeki, E.K.; Kobayashi, R.K.T.; Nakazato, G. Quorum sensing system: Target to control the spread of bacterial infections. Microb. Pathog. 2020, 142, 104068. [Google Scholar] [CrossRef] [PubMed]
- McLean, R.J.C.; Pierson, L.S.; Fuqua, C.; Iii, L.S.P. A simple screening protocol for the identification of quorum signal antagonists. J. Microbiol. Methods 2004, 58, 351–360. [Google Scholar] [CrossRef] [PubMed]
- Kalia, V.C. Quorum sensing inhibitors: An overview. Biotechnol. Adv. 2013, 31, 224–245. [Google Scholar] [CrossRef]
- Lu, X.-L.; Zhao, C.-H.; Yao, X.-L.; Zhang, H. Quercetin attenuates high fructose feeding-induced atherosclerosis by suppressing inflammation and apoptosis via ROS-regulated PI3K/AKT signaling pathway. Biomed. Pharmacother. 2017, 85, 658–671. [Google Scholar] [CrossRef]
- Xue, F.; Nie, X.; Shi, J.; Liu, Q.; Wang, Z.; Li, X.; Zhou, J.; Su, J.; Xue, M.; Chen, W.-D.; et al. Quercetin Inhibits LPS-Induced Inflammation and ox-LDL-Induced Lipid Deposition. Front. Pharmacol. 2017, 8, 40. [Google Scholar] [CrossRef]
- Liu, Y.; Li, Z.; Xue, X.; Wang, Y.; Zhang, Y.; Wang, J. Apigenin reverses lung injury and immunotoxicity in paraquat-treated mice. Int. Immunopharmacol. 2018, 65, 531–538. [Google Scholar] [CrossRef]
- Zhong, X.; Zhang, L.; Li, Y.; Li, P.; Li, J.; Cheng, G. Kaempferol alleviates ox-LDL-induced apoptosis by up-regulation of miR-26a-5p via inhibiting TLR4/NF-κB pathway in human endothelial cells. Biomed. Pharmacother. 2018, 108, 1783–1789. [Google Scholar] [CrossRef]
- Bouyahya, A.; Dakka, N.; Et-Touys, A.; Abrini, J.; Bakri, Y. Medicinal plant products targeting quorum sensing for combating bacterial infections. Asian Pac. J. Trop. Med. 2017, 10, 729–743. [Google Scholar] [CrossRef]
- Erhabor, C.; Erhabor, J.; McGaw, L. The potential of South African medicinal plants against microbial biofilm and quorum sensing of foodborne pathogens: A review. South. Afr. J. Bot. 2019, 126, 214–231. [Google Scholar] [CrossRef]
- Li, H.; Wang, S.; Yue, Z.; Ren, X.; Xia, J. Traditional Chinese herbal injection: Current status and future perspectives. Fitoterapia 2018, 129, 249–256. [Google Scholar] [CrossRef] [PubMed]
- Zhang, J.; Rui, X.; Wang, L.; Guan, Y.; Sun, X.; Dong, M.S. Polyphenolic extract from Rosa rugosa tea inhibits bacterial quorum sensing and biofilm formation. Food Control 2014, 42, 125–131. [Google Scholar] [CrossRef]
- Zhang, Q.; Rui, X.; Li, W.; Chen, X.; Jiang, M.; Dong, M.S. Anti-swarming and -biofilm activities of rose phenolic extract during simulated in vitro gastrointestinal digestion. Food Control 2016, 64, 189–195. [Google Scholar] [CrossRef]
- Packiavathy, I.A.S.V.; Agilandeswari, P.; Musthafa, K.S.; Pandian, S.K.; Ravi, A.V. Antibiofilm and quorum sensing inhibitory potential of Cuminum cyminum and its secondary metabolite methyl eugenol against Gram negative bacterial pathogens. Food Res. Int. 2012, 45, 85–92. [Google Scholar] [CrossRef]
- Packiavathy, I.A.S.V.; Priya, S.; Pandian, S.K.; Ravi, A.V. Inhibition of biofilm development of uropathogens by curcumin—An anti-quorum sensing agent from Curcuma longa. Food Chem. 2014, 148, 453–460. [Google Scholar] [CrossRef]
- Chusri, S.; Na Phatthalung, P.; Voravuthikunchai, S. Anti-biofilm activity of Quercus infectoria G. Olivier against methicillin-resistant Staphylococcus aureus. Lett. Appl. Microbiol. 2012, 54, 511–517. [Google Scholar] [CrossRef]
- Truchado, P.; Bastida, J.A.G.; Larrosa, M.; Castro-Ibáñez, I.; Espín, J.C.; Tomas-Barberan, F.; García-Conesa, M.-T.; Allende, A. Inhibition of Quorum Sensing (QS) in Yersinia enterocolitica by an Orange Extract Rich in Glycosylated Flavanones. J. Agric. Food Chem. 2012, 60, 8885–8894. [Google Scholar] [CrossRef]
- Durán, N.; Justo, G.Z.; Durán, M.; Brocchi, M.; Cordi, L.; Tasic, L.; Castro, G.R.; Nakazato, G. Advances in Chromobacterium violaceum and properties of violacein-Its main secondary metabolite: A review. Biotechnol. Adv. 2016, 34, 1030–1045. [Google Scholar] [CrossRef]
- Liu, Z.; Pan, Y.; Li, X.; Jie, J.; Zeng, M. Chemical composition, antimicrobial and anti-quorum sensing activities of pummelo peel flavonoid extract. Ind. Crops Prod. 2017, 109, 862–868. [Google Scholar] [CrossRef]
- De Kievit, T.R. Quorum sensing inPseudomonas aeruginosabiofilms. Environ. Microbiol. 2009, 11, 279–288. [Google Scholar] [CrossRef] [PubMed]
- Borges, A.; Serra, S.; Abreu, A.C.; Saavedra, M.J.; Salgado, A.; Simões, M. Evaluation of the effects of selected phytochemicals on quorum sensing inhibition andin vitrocytotoxicity. Biofouling 2013, 30, 183–195. [Google Scholar] [CrossRef] [PubMed]
- Almasoud, A.; Hettiarachchy, N.; Rayaprolu, S.; Babu, D.; Kwon, Y.M.; Mauromoustakos, A. Inhibitory effects of lactic and malic organic acids on autoinducer type 2 (AI-2) quorum sensing of Escherichia coli O157:H7 and Salmonella Typhimurium. LWT 2016, 66, 560–564. [Google Scholar] [CrossRef]
- Pothitirat, W.; Chomnawang, M.T.; Supabphol, R.; Gritsanapan, W. Free radical scavenging and anti-acne activities of mangosteen fruit rind extracts prepared by different extraction methods. Pharm. Biol. 2009, 48, 182–186. [Google Scholar] [CrossRef]
- Khan, M.; Zahin, M.; Hasan, S.; Husain, F.; Ahmad, I. Inhibition of quorum sensing regulated bacterial functions by plant essential oils with special reference to clove oil. Lett. Appl. Microbiol. 2009, 49, 354–360. [Google Scholar] [CrossRef]
- Zhang, J.; Wang, H.; Huang, Q.; Zhang, Y.; Zhao, L.; Liu, F.; Wang, G. Four superoxide dismutases of Bacillus cereus 0–9 are non-redundant and perform different functions in diverse living conditions. World J. Microbiol. Biotechnol. 2020, 36, 12. [Google Scholar] [CrossRef]
- Gao, T.; Ding, M.; Yang, C.-H.; Fan, H.; Chai, Y.; Li, Y. The phosphotransferase system gene ptsH plays an important role in MnSOD production, biofilm formation, swarming motility, and root colonization in Bacillus cereus 905. Res. Microbiol. 2019, 170, 86–96. [Google Scholar] [CrossRef]
- Zhang, J.; Xiao, Y.; Guan, Y.; Rui, X.; Zhang, Y.; Dong, M.; Ma, W. An aqueous polyphenol extract from Rosa rugosa tea has antiaging effects on Caenorhabditis elegans. J. Food Biochem. 2019, 43, e12796. [Google Scholar] [CrossRef]
Sample Availability: Samples of the compounds are available from the authors. |

| Inhibition Zone of Purple | Transparent Zone | |
|---|---|---|
| Campsis grandiflora | +++ | - |
| Panax notoginseng flower | ++ | - |
| Buddleja officinalis flower | ++ | - |
| ,Pueraria lobate flower | ++ | - |
| Lonicera japonica Thunb. | ++ | - |
| Sophora japonica Linn flower | + | ++ |
| Crocus sativus L. | + | - |
| Lavandula angustifolia Mill. | + | - |
| Jasminum sambac (L.) Ait. | + | - |
| Chimonanthus praecox | + | ++ |
| Dendranthema morifolium (Ramat.) Tzvel. | + | + |
| Prunus persica | ++ | - |
| CFEE Concentration | 50 μg/mL | 100 μg/mL | 200 μg/mL | |||
|---|---|---|---|---|---|---|
| Diameter (mm) | Inhibited Rate (%) | Diameter (mm) | Inhibited Rate (%) | Diameter (mm) | Inhibited Rate (%) | |
| E. coli K-12 | 75.4 ± 0.8 | 16.41 | 50.7 ±1.3 | 43.79 | 8.3 ± 0.3 | 90.80 |
| P. aerugionsa PAO1 | 28.7 ± 1.1 | 37.74 | 26.5 ± 0.2 | 42.52 | 5.1 ± 0.1 | 88.94 |
| Peak No. | RT (min) | Molecular Weight | Molecular Formula | Δmass (ppm) | Tentative Identification | mzVault Match | Content (%Area) |
|---|---|---|---|---|---|---|---|
| 1 | 8.154 | 132.05 | C4H8N2O3 | −10 | Asparagine | 95.9 | 0.620 |
| 2 | 8.585 | 208.06 | C4H4N10O | - | Unknown | - | 0.129 |
| 3 | 8.628 | 194.04 | C6H10O7 | −3.41 | Glucuronic acid | 64.0 | 7.467 |
| 4 | 8.973 | 192.06 | C7H12O6 | −5.03 | Quinic acid | 91.8 | 15.090 |
| 5 | 9.017 | 192.03 | C6H8O7 | −2.91 | Citric acid | 94.0 | 2.739 |
| 6 | 9.237 | 106.03 | C3H6O4 | −14.31 | Glyceric acid | 87.3 | 7.502 |
| 7 | 9.785 | 134.02 | C4HO5 | −10.1 | Malic acid * | 97.0 | 16.948 |
| 8 | 12.925 | 261.08 | C10H15NO7 | - | Hymexazol O-glucoside | - | 0.021 |
| 9 | 16.739 | 118.03 | C4H6O4 | −4.27 | Succinic acid * | 96.2 | 6.964 |
| 10 | 18.071 | - | - | - | Unknown | - | 0.198 |
| 11 | 18.204 | 316.08 | C13H16O9 | 2.96 | NP-020139 | 67.0 | 0.246 |
| 12 | 18.617 | 170.02 | C7H6O5 | −6.16 | Gallic acid | - | 0.167 |
| 13 | 19.742 | 356.11 | C16H20O9 | UN | Gentiopicrin | 73.9 | 0.124 |
| 14 | 19.939 | 624.20 | C29H36O15 | −1.88 | Verbascoside | 92.1 | 26.438 |
| 15 | 20.134 | 166.03 | C8H6O4 | −6.89 | Isophthailc acid | 81.5 | 0.190 |
| 16 | 20.622 | 180.04 | C9H8O4 | −5.39 | Caffeic acid * | 94.0 | 6.377 |
| 17 | 20.924 | 138.03 | C7H6O3 | −9.31 | Salicylic acid | 86.3 | 1.414 |
| 18 | 22.163 | 164.05 | C9H8O3 | −0.14 | Coumaric acid | 79.4 | 1.260 |
| 19 | 22.543 | 194.06 | C10H10O4 | −3.42 | Ferulic acid | 94.7 | 1.276 |
| 20 | 22.706 | 164.05 | C9H8O3 | −6.5 | Coumaric acid | 91.6 | 0.309 |
| 21 | 23.477 | 146.04 | C9H6O2 | - | Coumarin | 57.9 | 0.778 |
| 22 | 24.275 | 145.05 | C9H7NO | −8.84 | 4-Indolecarbaldehyde | 77.4 | 0.207 |
| 23 | 24.591 | 328.22 | C18H32O5 | −2.74 | Corchorifatty acid | 89.4 | 3.537 |
Publisher’s Note: MDPI stays neutral with regard to jurisdictional claims in published maps and institutional affiliations. |
© 2020 by the authors. Licensee MDPI, Basel, Switzerland. This article is an open access article distributed under the terms and conditions of the Creative Commons Attribution (CC BY) license (http://creativecommons.org/licenses/by/4.0/).
Share and Cite
Zhang, J.; Xu, F.; Yao, L.; Wang, L.; Wang, M.; Wang, G. Ethanol Extract of Campsis grandiflora Flower and Its Organic Acid Components Have Inhibitory Effects on Autoinducer Type 1 Quorum Sensing. Molecules 2020, 25, 4727. https://doi.org/10.3390/molecules25204727
Zhang J, Xu F, Yao L, Wang L, Wang M, Wang G. Ethanol Extract of Campsis grandiflora Flower and Its Organic Acid Components Have Inhibitory Effects on Autoinducer Type 1 Quorum Sensing. Molecules. 2020; 25(20):4727. https://doi.org/10.3390/molecules25204727
Chicago/Turabian StyleZhang, Juanmei, Fenghua Xu, Lingling Yao, Leyu Wang, Miao Wang, and Gang Wang. 2020. "Ethanol Extract of Campsis grandiflora Flower and Its Organic Acid Components Have Inhibitory Effects on Autoinducer Type 1 Quorum Sensing" Molecules 25, no. 20: 4727. https://doi.org/10.3390/molecules25204727
APA StyleZhang, J., Xu, F., Yao, L., Wang, L., Wang, M., & Wang, G. (2020). Ethanol Extract of Campsis grandiflora Flower and Its Organic Acid Components Have Inhibitory Effects on Autoinducer Type 1 Quorum Sensing. Molecules, 25(20), 4727. https://doi.org/10.3390/molecules25204727
